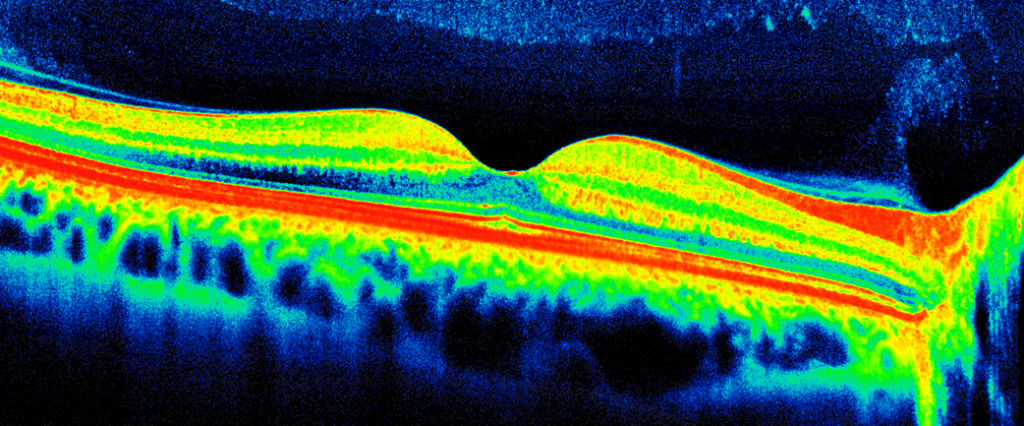
Macular-OCT

Plaquenil & Other Medication Screenings
If you are taking a medication that is deemed as “Higher Risk for Side Effects,” your rheumatologist may require you to have an annual dilated eye examination with visual fields and retina scans to monitor for changes related to your medications. We offer these services and communicate all findings to your managing physician.
Medication Screening Eye examinations
If you are taking a medication that is deemed as “Higher Risk for Side Effects,” your rheumatologist may require you to have an annual dilated eye examination with visual fields and retina scans to monitor for changes related to your medications. We offer these services and communicate all findings to your managing physician.
Fundus Photo

The inside, back surface of the eye that contains the retina, macula, optic disc, fovea and blood vessels.
Macular OCT
A non-invasive imaging test that uses light waves to capture cross-section pictures of your retina; this allows your ophthamologist to see each distinct layer of your retina.
Visual Field Print Out

The entire area that can be seen when your eye is fixed to a certain point.

Ready to Schedule Your Medication Screening?
To ensure that we can provide the necessary documentation for your primary care physician, please inform our staff when scheduling your appointment that you need a medication screening. We will coordinate with your doctor to ensure a seamless process.